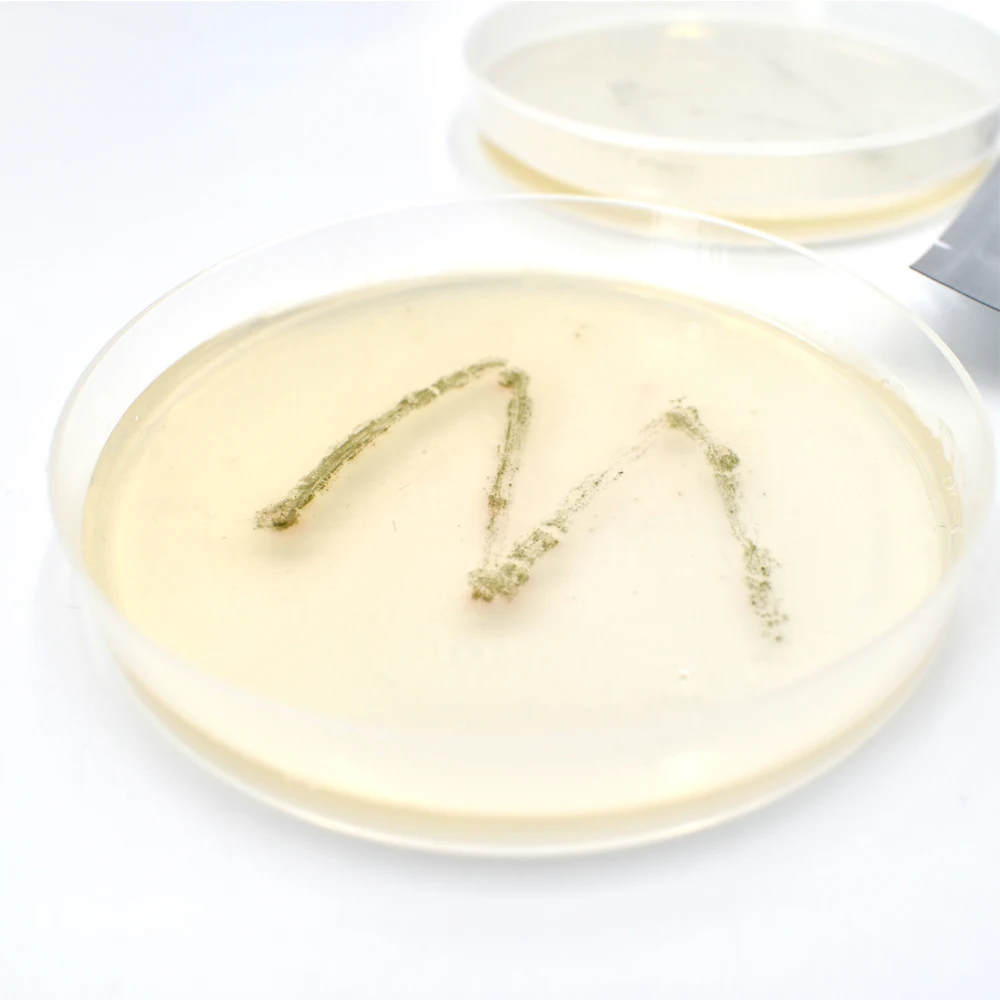

Набор детективов для детей развивающие игрушки химии Забавный набор научных
- Категория: >>>
- Поставщик: Xinxiang,Alpha,Manufacturing,Ltd.
Поделиться:
Описание и отзывы
Трекер стоимости
| Месяц | Минимальная цена | Макс. стоимость |
|---|---|---|
| Sep-16-2025 | 7.35 $* | 7.5 $* |
| Aug-16-2025 | 7.7 $* | 7.13 $* |
| Jul-16-2025 | 6.49 $* | 6.64 $* |
| Jun-16-2025 | 7.2 $* | 7.43 $* |
| May-16-2025 | 6.49 $* | 6.63 $* |
| Apr-16-2025 | 7.15 $* | 7.9 $* |
| Mar-16-2025 | 7.18 $* | 7.94 $* |
| Feb-16-2025 | 7.96 $* | 7.12 $* |
| Jan-16-2025 | 7.67 $* | 7.26 $* |
Характеристики
Alpha---Educational Science Toys Series
1. Big Bang Science combines the science of chemistry, physic, astronomy, geography, etc. into the educational toy, it makes children have more fun with science in the budding age.
2. All the science kits make the STEM education much more easier and funny for each family.
3. Children can learn much science knowledge while playing with our educational science kit.
4. All the products are produced under the quality principle of AQL 1.5 and comply the testing standards of ASTM F963, EN71, AS/NZS, etc.
detective kit for kids chemistry education toys fun scientific game set
When the policemen trace the traces in the crime scene, a piece of hair,fingerprint or footprint all can reveal the whereabouts of the criminals and finally find them. Now, it’s time to the detective to show their skills.The Detective is a mysterious job who can find the tiny clues, missing evidences and invisible traces. This kit will invite you to enter the scene of the crime, you will be the real detective after the training in this kit. Let us explore the unknown secret from this kit!
There are 14 activities below in this kit:
Activity 1: Sharp observation
Activity 2: Trace the traces
Activity 3: Tracing investigation
Activity 4: The extraction of fingerprint
Activity 5: Comparison of fingerprint
Activity 6: The comparison of DNA
Activity 7: The cultivation of microorganism
Activity 8: The biology in the pond
Activity 9: Sunk paper
Activity 10: The habit of handwriting
Activity 11: The dispersion of handwriting
Activity 12: Secret liquid
Activity 13: Height and foot
Activity 14: Make your own footprint mould
| Description | detective kit for kids chemistry education toys fun scientific game set |
| Item No. | SR16107 |
| Style | educational toys |
| Packing | Color Box |
Packing Size(cm) | 29.5*26.5*7 cm |
| Set/Carton | 6 Sets |
CBM/Carton(m³) | 0.041 m³ |
| Gross Weight(kgs) | 2.82 kg |
| Net Weight(kgs) | 2.25 kg |
| Standard | ASTM F963, EN71, AS/NZS, etc. |
| Suit for age | 8 + |
| OEM & ODM | Available |
| Sample Time | 2 - 5 days |
| Production Time | 15 - 45 days, according to order quantity. |






Q: What is the MOQ?
A: 1008 sets for regular size kit.
Q: How to send the goods?
A: We usually send the goods by Sea in FLC or LCL, and we also would send the goods by air or express.
Q: How to get the sample?
A: You may inform us the item number of the sample you would like to have, we will feedback with sample invoice ( if there is some sample cost.)
Q: Do you provide OEM service?
A: Yes, we have many years of experience in making OEM orders.
Q: What is the loading port?
A: Qingdao , Tianjin, Shanghai , Ningbo.
Q: Can I get a few samples before placing the order?
A: Yes, we can offer samples as your request. We will collect sample fees and refund after you place the order.
Q: What about the lead time for mass production?
A: It depends on the order quantity and the season you place the order. The regular lead time is 45 days after we receive the pass test report or the payment.
Q: What is your product warranty?
A: We guarantee the products customers received are qualified. If there are any broken parts, please send us some detailed photo by E-mail, and then we will send you the replacement parts according to the actual conditions.
![]()